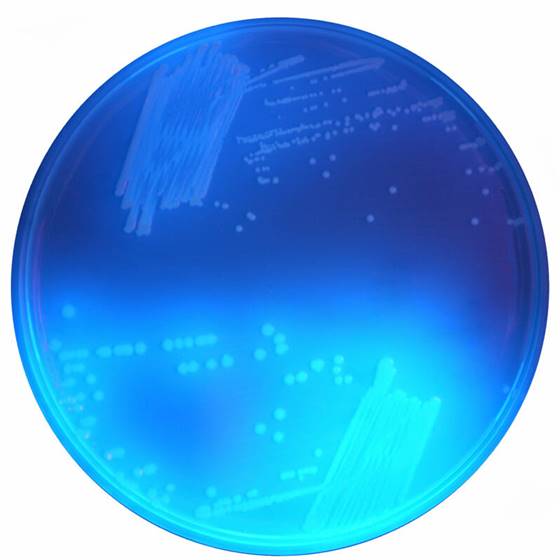

Über das Produkt
Chromogenes Medium zum Nachweis von Clostridium difficile.
Ähnliche Produkte
CHROMagar C.difficile (5L)
CHROMagar C.difficile Fertigplatten
Chromogenes Medium zum Nachweis von Clostridium difficile.
CHROMagar C.difficile (5L)